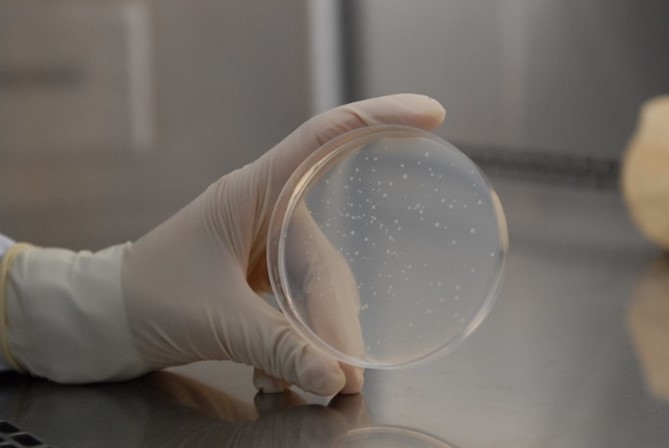
新闻图片3

13 年
手机商铺
公司新闻/正文
320 人阅读发布时间:2024-05-23 11:18
细菌回复突变试验(Bacterial Reverse Mutation Test),亦称Ames试验,于1975年由美国加利福尼亚大学伯克利分校生化系B.N.Ames教授实验室建立并不断发展完善,至今已成为国际上通用的遗传毒理评价体系的必检项目,同时也是许多遗传毒理学新兴技术发展过程中对照验证结果的试验之一,广泛应用于化合物的致突变性和潜在致癌性的初筛检验。
一、Ames试验简介
Ames试验是以营养缺陷型的突变体菌株为指示生物来检测基因突变的体外试验,可预测受试物的遗传毒性和潜在致癌性。常用的菌株有组氨酸营养缺陷型鼠伤-寒沙-门氏菌和色氨酸营养缺陷型的大肠杆菌。
其原理是利用鼠伤-寒沙-门氏菌和大肠杆菌来检测点突变,涉及DNA的一个或几个碱基对的置换、插入或缺失。鼠伤-寒沙-门氏菌和大肠杆菌试验菌株在无组氨酸或色氨酸的培养基上不能生长,在有组氨酸或色氨酸的培养基上才能正常生长。致突变物存在时可将营养缺陷型菌株回复突变为原养型,即在无组氨酸或色氨酸的培养基上也能正常生长。因此可根据菌株形成数量来判断受试物是否具有致突变作用。同时,受试物检测应在有和没有代谢活化系统的条件下进行试验,因为某些致突变物仅在有代谢活化后才能发生细菌回复突变情况。

二、IPHASE相关产品
Ames试验的开展主要参照OECD标准、国家标准或指导原则等,试验流程复杂,试验所需试剂多样且制备繁琐,要保证试验结果稳定、可靠、可重现性良好往往需要丰富的经验和不断的数据积累,要完成一次理想的试验往往需要耗费大量的人力、物力及资源,故常常令科研工作者望而却步。
因此,IPHASE作为体外研究生物试剂引领者,凭借多年的经验和专业的技术人才,遵循食品、农药、化学品、化妆品、医疗器械及药品等多个方向的国家遗传毒性研究技术指导原则,开发了一系列不同领域下的Ames试验组分试剂盒,确保其内组分、浓度及名称等信息均完全匹配国家标准,为广大客户省去了溶液配制时间,大大缩短了试验周期。

便捷性
省去试剂配制的时间,可以直接使用,大大缩短了实验周期。
准确性
试剂盒各成分均经过严格的质量检测,实验结果准确、可靠、重现性高。
稳定性
试剂盒稳定性强、易于运输和保存。
应用广
应用范围广,可用于食品、药品、化妆品、化学品、医疗器械、农药等的遗传毒性研究。
此外,针对拓展项目等初次接触细菌回复突变试验或暂无菌株等数据、经验积累的客户,IPHASE同时推出针对食品、农药、化学品、化妆品、医疗器械及药品等不同领域下的新升级版标准Ames试验试剂盒,其内组分、浓度及名称完全匹配特定领域下的细菌回复突变试验国家标准。IPHASE将营养缺陷型菌株固态化(冻存菌液)、将代谢活化系统简便化、将所有配套试剂成品化,真正实现了“一站式”试验的目的。同时根据不同的试验目的,IPHASE也推出了不同规格的产品,可满足客户的不同需求。
本次开发、升级产品将于6月准时上线,在此,IPHASE期待与不同领域下客户的深入交流,望广大客户敬请期待!
IPHASE/汇智和源凭借多年的研发经验,推出了多领域、多种类的高端科研试剂,为药物早期研发提供筛选工具,为生命科学领域的探索提供新材料、新方法和新手段,为食品、药品、化学品等的遗传毒性研究提供便捷产品,望广大科研工作者来电咨询,咨询热线400-127-6686。
发 文 章 得 奖 励
凡使用本公司产品,在国内及国际刊物上发表论文(论文发表日起一年内),并注明产品属于IPHASE BIOSCIENCES CO,LTD / 汇智和源生物技术(苏州)有限公司所有,即可申请奖励。根据发表刊物影响因子不同,给予不同金额奖品:
非SCI论文及IF≤5分,500元礼品;
5分<IF≤8分 800元;
8分<IF≤10分 1000元;
IF≥10分 2000元;
注:礼品卡也可兑换同等金额产品购买抵用券;
活动多多,礼品丰厚,快来参与吧!
关 于 我 们
汇智和源,致力于为创新药研发企业及生命科学研究机构提供高品质的生物试剂,IPHASE为公司核心品牌,品牌宗旨“Innovative Reagents For Innovative Research”。